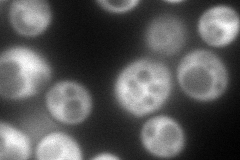
YGL014W
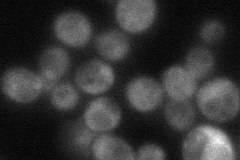
YGL014W
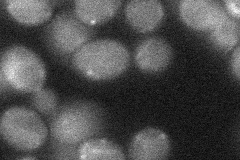
YGL014W
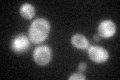
YGL014W
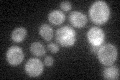
YGL014W

View description
Member of the PUF protein family, which is defined by the presence of Pumilio homology domains that confer RNA binding activity; preferentially binds mRNAs encoding nucleolar ribosomal RNA-processing factors
Localization:
Intensity:
Fold change:
Significance:
-
C’ GFP library in SD

cytosol56.2 -
N' NOP1pr-GFP in SD
cytosol169.398 -
N' TEF2pr-mCherry in SD

cytosol92.0075 -
N' NATIVEpr-GFP in SD
cytosol49.9907 -
N' TEF2pr-VC and Cyto-VN in SD
below threshold26.2677 -
C’ GFP library in SD+DTT

cytosol44.750.79No -
C’ GFP library in SD+H2O2
cytosol56.140.99No -
C’ GFP library in Starvation Media
cytosol34.180.6No -
C’ GFP library on the background of Pup2-DaMP

cytosol -
C’ GFP library on the background of CCT mutant

cytosol58.89041.04779No
